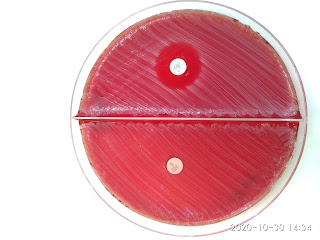

La primera prueba que hicimos fue la de la catalasa. La catalasa es una enzima que proteje a las células frente al peróxido de hidrógeno producido en el metabolismo del oxígeno. Cataliza la formación de agua y oxígeno a partir del peróxido de hidrógeno. Es util para distinguir Streptococcus (negativa) de Staphylococcus (positiva).
La actividad catalasa se detecta añadiendo unas gotas de peróxido de hidrógeno sobre las colonias en placa que no sea de agar sangre (daría falsos positivos). La producción de burbujas indica la presencia del enzima. Burbujas: catalasa positivo.
La prueba de la coagulasa. La coagulasa es un enzima capaz de desnaturalizar la fibrina del plasma. Los Staphylococcus aureus patógenos dan una reacción positiva y los no patógenos negativa
Se añade una suspensión densa de bacterias a un tubo pequeña con plasma y se incuba a 37 oC. Se observa la coagulación a las 4 y 24 h sin sacarlos de la estufa.
S. aureus produce dos formas de coagulasa, una que se encuentra ligada a la membrana (coagulasa ligada, ya revisada) y otra coagulasa libre.
La coagulasa libre, a diferencia de la coagulasa ligada, no cataliza la reacción directa entre fibrinógeno y fibrina, su mecanismo de acción es modificar el factor de reacción con la coagulasa a estafilotrombina, un producto semejante a la trombina.
Estafilotrombina es el factor que cataliza la conversión de fibrinógeno a fibrina, que formará un coágulo rodeando las células de S. aureus impidiendo que las células inmunológinas del hospedador entren en contacto con la bacteria e inicien la fagocitosis.
A la izquierda tenemos a S. aureus que produjo coagulación y a la derecha tenemos a S. epidermidis que no produjo coagulación. La coagulasa reacciona con la protrombina en la sangre. El complejo resultante se llama estafilotrombina, y permite que la enzima proteasa convierta el fibrinógeno en fibrina. Esto hace que se coagule la sangre. La coagulasa está estrechamente relacionada con la superficie de la bacteria.
La siguiente prueba será la presencia de DNasa. Algunas bacterias excretan nucleasas que despolimerizan el DNA. Se hace una estría gruesa una placa conteniendo DNA. Se revela después de incubar con HCL 0,1 N que precipita el DNA no hidrolizado
Pregunta 1: ¿Por qué tiene color dorado el S. aureus? ¿Qué función tienen generalmente estos pigmentos?
El color amarillo es debido a pigmentos carotenoides. La síntesis de productos coloreados por parte de los microorganismos es una característica determinada genéticamente. Su formación en muchos microorganismos es dependiente de la presencia de la luz, composición del sustrato y la temperatura de incubación. La presencia de pigmentos en las bacterias que medran en hábitats sometidos a la luz les confieren un efecto protector frente a la luz visible y el ultravioleta cercano. Los carotenoides se localizan en la membrana plasmática y protegen a la célula de la fotooxidación, su presencia confiere a las bacterias colores que van desde el tono amarillo al rojo.Pregunta 2: Queremos distinguir S. aureus de Streptococcus pyogenes. Los crecemos en agar sangre y realizamos la prueba de la catalasa. ¿Por qué debemos tener cuidado cuando tomamos una colonia de no tomar agar sangre?
La actividad catalasa se detecta añadiendo unas gotas de peróxido de hidrógeno sobre las colonias en placa que no sea de agar sangre ya que los eritrocitos poseen catalasa, lo cual nos daría falsos positivos.
Pregunta 3: ¿Qué le pasa al ADN cuando añadimos ácido clorhídrico? ¿Qué efecto tiene la DNasa en el este efecto?

No hay comentarios:
Publicar un comentario
Cada vez que lees un artículo y no dejas un comentario, alguien mata a un gatito en alguna parte del mundo...